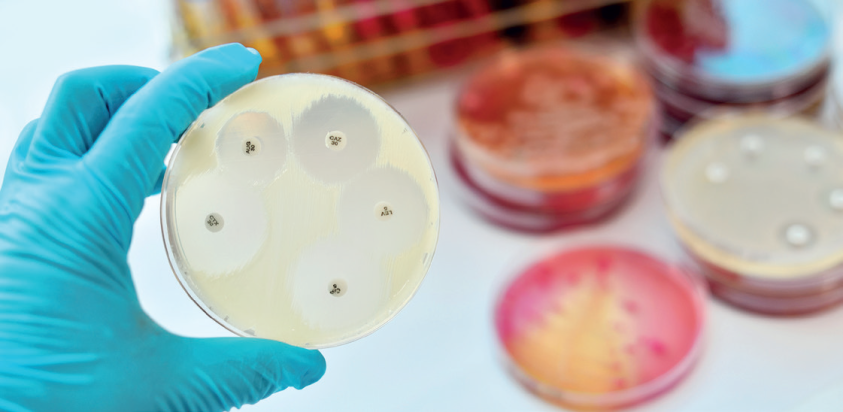
Bez názvu

Pneumokok jako původce pneumonií není problémem pouze u rizikové populace
Invazivní pneumokokové infekce (IPO) jsou celosvětově významným faktorem morbidity i mortality. Nejvýznamnější riziko představují pro malé děti, seniory, pacienty s komorbiditami nebo imunosuprimované osoby. I přes údaje o závažnosti IPO a dostupnosti vícevalentních pneumokokových konjugovaných vakcín je proočkovanost v ČR dosud nízká navzdory úhradě či finančnímu příspěvku pro rizikové osoby. Podle dostupných dat Ústavu zdravotnických informací z roku 2021 byla u seniorů nad 65 let pouze 25% a u vysoce rizikových aspleniků tohoto věku jen 65,4%. Závažné pneumokokové infekce však nepostihují pouze seniory a rizikové nemocné.
Již téměř dvě desetiletí je dostupná vakcinace konjugovanými vakcínami. Již před jejím zavedením do očkovacího kalendáře kojenců i rizikových dospělých byla k dispozici celá řada epidemiologických studií potvrzujících míru rizika invazivní pneumokokové infekce a následně byl robustními daty prokázán benefit vakcinace pro incidenci invazivních onemocnění. V zemích, kde je proočkovanost vyšší než v České republice, lze pozorovat rovněž vliv vakcinace na nosičství vakcinačních sérotypů včetně nepřímého vlivu na četnost neinvazivních forem onemocnění. Incidenci invazivních pneumokokových infekcí lze relativně přesně posuzovat podle zachycených případů meningitid, bakteriemických pneumonií a sepsí, i když tato data mohou být též zkreslena klinickou praxí a zvyklostmi odběru biologického materiálu před zahájením antibiotické léčby. Ve vyspělých zemích se udává 10–50 případů IPO na 100 000 obyvatel za rok. Nicméně odhadnout přesnější incidenci pneumokokových pneumonií je výrazně obtížnější, protože naprostá většina z nich je nebakteriemických.
Tudíž i dle studií se jejich incidence udává v rozpětí od 68 do 7 000 na 100 000 obyvatel za rok. Podle diagnostických kritérií se pneumonie diagnostikují jako pneumokokové především na podkladě pozitivní kultivace hemokultury, nálezu v aspirátu, v laváži, případně ve sputu. Modernější, ale méně vypovídající s ohledem na antibiotickou citlivost nebo sérotypizaci je metoda přímého průkazu PCR (polymerázová řetězová reakce) v uvedených biologických materiálech. Nejméně spolehlivou možností je průkaz antigenu v moči. Zkresluje ho časté nosičství pneumokoků u dětí (v kolektivech 40–80 % dětí), u dospělých má vyšší výpovědní hodnotu (pouze 5–10 % nosičů). V praxi se na pneumokokový původ pneumonie usuzuje dle typického rentgenologického (rtg) nálezu segmentální nebo lobární pneumonie podpořené významným vzestupem hodnot zánětlivých parametrů. Častou komplikací pneumokokových pneumonií je fluidothorax, empyém nebo i riziko respiračního selhání. Kromě vyššího věku je prokázaným rizikem komplikace infekce vyvolaná některými sérotypy, především 3, 19A a 19F.
V České republice, v souladu s daty z jiných zemí, došlo během pandemie covidu‑19 v důsledku protiepidemických opatření k významnému poklesu výskytu invazivních onemocnění s přenosem respirační cestou. Avšak v roce 2022 již četnost těchto infekcí včetně IPO přesáhla předcovidové období. Nejvíce případů IPO bylo prokázáno u pacientů ve věku od 65 let (244 ze 472 případů), s nemocností 11,1/100 000 obyvatel. Celková smrtnost v souvislosti s IPO dosáhla 17,6 %; 83 úmrtí. Dlouhodobě nejčastěji zastoupený sérotyp způsobující IPO, tj. sérotyp 3, byl prokázán ve 20 případech. Ve věkové skupině 65+ (55 úmrtí) dosáhla smrtnost až 22,5 %.
Kazuistika
Sedmačtyřicetiletá pacientka byla přijata na Kliniku infekčních nemocí po ambulantním vyšetření na jiném pracovišti. Anamnesticky byla bez pozoruhodností, bez komorbidit, kromě cholecystektomie v minulosti. Primárně byla vyšetřena pro febrilie, palpitace, dušnost, řídké stolice. Obtíže trvaly pouze jeden den. Antigenní test na covid‑19 byl negativní. Byla provedena sonografie břicha, kde byla popsána hepatomegalie a difuzní jaterní léze obrazu steatózy, bez dilatace žlučových cest. Moč nezánětlivá. Byl proveden rovněž skiagram hrudníku s přiměřeným nálezem. Pracovní diagnózou při přijetí na standardní oddělení byl febrilní stav nejasné etiologie.
 Vstupní laboratorní hodnoty po přijetí byly následující: krevní obraz bez leukocytózy, ale s výraznou neutrofilií, 36 % neutrofilních tyčí, NLR (neutro/lymfo counts ratio) 18,5, C‑reaktivní protein (CRP) 360 mg/l, prokalcitonin (PCT) 4,9 mg/l, lehká elevace transamináz, GGT (gama‑glutamyltransferáza) 6,72 μkat/l, proto byly odebrány vzorky k sérologické diagnostice hepatitidy. V klinickém obraze však dominovala dušnost a hyposaturace při pozitivní DD (zvýšené hladině D‑dimerů). Následně bylo doplněno vyšetření pomocí CT angiografie plic, kde byl sice doložen nález bez známek plicní embolizace, byla však popsána zánětlivá konsolidace větší části levého dolního laloku, prchavé infiltráty i v centrální části všech laloků pravé plíce a levostranný fluidothorax. Z laboratoře byl hlášen slabě pozitivní pneumokokový antigen v moči, pacientka byla zajištěna empiricky ampicilinem s doxycyklinem. Z pěti lahviček hemokultur byl vykultivován Streptococcus pneumoniae, doxycyklin byl tudíž vysazen, antibiotická léčba byla deeskalována na krystalický peniclin G. PCR test výtěrem z nosohltanu opět potvrdil pozitivní Str. pneumoniae. Na zvolené terapii se klinický stav zlepšuje, průtoky kyslíku se snižují. V kontrolní laboratoři byla nově zjištěna výrazná leukocytóza s neutrofilií, hodnoty zánětlivých parametrů sice v poklesu – CRP 257,8 mg/l, PCT v normě, ale došlo ke zhoršení dušnosti a bolestí levé poloviny hrudníku. Rtg plic ze dne 27. října 2023 – zastření celého levého hemithoraxu – progrese výpotku (obr. 1); 28. října – zhoršení dušnosti. Zamýšlená hrudní drenáž pod ultrasonografickou kontrolou nebyla vzhledem k septaci výpotku provedena. Doplněno vyšetření výpočetní tomografií (CT) hrudníku s nálezem rozsáhlých septovaných tekutinových kolekcí (obr. 2) – po dohodě s pneumologem a chirurgem byla pacientka indikována k drenáži hrudním chirurgem. Do terapie byl přidán linezolid*. Dne 30. října byl pod sonografickou kontrolou zaveden hrudní drén v cca 6./7. mezižebří ve střední axilární čáře vlevo, drén odvedl žlutavou lehce kalnou tekutinu, celkem cca 1 500 ml, dne 31. října si pacientka drén zrušila; 31. října bylo provedeno kontrolní sonografické vyšetření hrudníku – laterálně v místě drénu lem tekutiny v podkoží, atelektatická plíce, bazálně z dorzální strany nad bránicí 20–30 mm lemu tekutiny, max. paravertebrálně, fibrinová vlákna.
Vstupní laboratorní hodnoty po přijetí byly následující: krevní obraz bez leukocytózy, ale s výraznou neutrofilií, 36 % neutrofilních tyčí, NLR (neutro/lymfo counts ratio) 18,5, C‑reaktivní protein (CRP) 360 mg/l, prokalcitonin (PCT) 4,9 mg/l, lehká elevace transamináz, GGT (gama‑glutamyltransferáza) 6,72 μkat/l, proto byly odebrány vzorky k sérologické diagnostice hepatitidy. V klinickém obraze však dominovala dušnost a hyposaturace při pozitivní DD (zvýšené hladině D‑dimerů). Následně bylo doplněno vyšetření pomocí CT angiografie plic, kde byl sice doložen nález bez známek plicní embolizace, byla však popsána zánětlivá konsolidace větší části levého dolního laloku, prchavé infiltráty i v centrální části všech laloků pravé plíce a levostranný fluidothorax. Z laboratoře byl hlášen slabě pozitivní pneumokokový antigen v moči, pacientka byla zajištěna empiricky ampicilinem s doxycyklinem. Z pěti lahviček hemokultur byl vykultivován Streptococcus pneumoniae, doxycyklin byl tudíž vysazen, antibiotická léčba byla deeskalována na krystalický peniclin G. PCR test výtěrem z nosohltanu opět potvrdil pozitivní Str. pneumoniae. Na zvolené terapii se klinický stav zlepšuje, průtoky kyslíku se snižují. V kontrolní laboratoři byla nově zjištěna výrazná leukocytóza s neutrofilií, hodnoty zánětlivých parametrů sice v poklesu – CRP 257,8 mg/l, PCT v normě, ale došlo ke zhoršení dušnosti a bolestí levé poloviny hrudníku. Rtg plic ze dne 27. října 2023 – zastření celého levého hemithoraxu – progrese výpotku (obr. 1); 28. října – zhoršení dušnosti. Zamýšlená hrudní drenáž pod ultrasonografickou kontrolou nebyla vzhledem k septaci výpotku provedena. Doplněno vyšetření výpočetní tomografií (CT) hrudníku s nálezem rozsáhlých septovaných tekutinových kolekcí (obr. 2) – po dohodě s pneumologem a chirurgem byla pacientka indikována k drenáži hrudním chirurgem. Do terapie byl přidán linezolid*. Dne 30. října byl pod sonografickou kontrolou zaveden hrudní drén v cca 6./7. mezižebří ve střední axilární čáře vlevo, drén odvedl žlutavou lehce kalnou tekutinu, celkem cca 1 500 ml, dne 31. října si pacientka drén zrušila; 31. října bylo provedeno kontrolní sonografické vyšetření hrudníku – laterálně v místě drénu lem tekutiny v podkoží, atelektatická plíce, bazálně z dorzální strany nad bránicí 20–30 mm lemu tekutiny, max. paravertebrálně, fibrinová vlákna.
 Pacientka se však zhoršila po stránce vědomí, celkově neklidná, nadále byla ponechána bez drenáže, byla zahájena dechová rehabilitace a do léčby přidány kortikoidy. Pro stav zmatenosti byl krystalický penicilin vysazen, nasazen ceftriaxon, pacientka na jednotce intenzivní péče tlumena kombinací midazolam + dexmedetomidin + klomethiazol. Ještě před nasazením kortikoidů se v krevním obraze objevuje narůstající trombocytóza – až 1 260 × 109/l, zahájena duální agregace. V dalším průběhu dochází ke zlepšení klinického stavu, HFNO (vysokoprůtoková aplikace kyslíku) se snižujícím průtokem. Dne 2. listopadu 2023 proběhlo kontrolní CT vyšetření s drenáží tekutinové kapsy, drén odvedl cca 120 ml serózní tekutiny, stav pacientky byl zlepšen, na oxygenoterapii nízkoprůtokovým kyslíkem brýlemi. Drén po odvodu menšího množství serózní tekutiny byl dále zrušen. Pro další vzestup hodnot aminotransferáz a amyláz byla rovněž ukončena terapie ceftriaxonem. Pokračuje dechová a pohybová rehabilitace, 7. listopadu byly pacientce zrušeny invazivní vstupy, 8. listopadu byla ukončena terapie linezolidem*, tudíž celkově byla účinná terapie podávána 21 dnů. Kortikoidy detrahovány. Kontrolním ultrazvukovým vyšetřením byl zjištěn výpotek mezi 16–21 mm, nevhodný k punkci, ponecháváme ke spontánní úpravě a observaci. Pacientka byla přeložena na standardní oddělení, kde bylo pokračováno v symptomatické terapii a rehabilitacích. Klinický stav byl zlepšen. V kontrolní laboratoři tendence úpravy jaterních obstrukčních enzymů, amylázy i lipázy, minimální vzestup hodnoty CRP bez klinické korelace. V krevním obraze trvající leukocytóza až 17 × 109/l pravděpodobně při kortikoterapii. Hodnoty trombocytů již skoro normalizovány, duální antiagregace ukončena. Pro epizodu asymptomatické tachykardie byl podán betablokátor. Pacientka byla již dále afebrilní, oběhově stabilizovaná, normosaturovaná. Byla propuštěna do domácí péče za ambulantních pneumologických kontrol.
Pacientka se však zhoršila po stránce vědomí, celkově neklidná, nadále byla ponechána bez drenáže, byla zahájena dechová rehabilitace a do léčby přidány kortikoidy. Pro stav zmatenosti byl krystalický penicilin vysazen, nasazen ceftriaxon, pacientka na jednotce intenzivní péče tlumena kombinací midazolam + dexmedetomidin + klomethiazol. Ještě před nasazením kortikoidů se v krevním obraze objevuje narůstající trombocytóza – až 1 260 × 109/l, zahájena duální agregace. V dalším průběhu dochází ke zlepšení klinického stavu, HFNO (vysokoprůtoková aplikace kyslíku) se snižujícím průtokem. Dne 2. listopadu 2023 proběhlo kontrolní CT vyšetření s drenáží tekutinové kapsy, drén odvedl cca 120 ml serózní tekutiny, stav pacientky byl zlepšen, na oxygenoterapii nízkoprůtokovým kyslíkem brýlemi. Drén po odvodu menšího množství serózní tekutiny byl dále zrušen. Pro další vzestup hodnot aminotransferáz a amyláz byla rovněž ukončena terapie ceftriaxonem. Pokračuje dechová a pohybová rehabilitace, 7. listopadu byly pacientce zrušeny invazivní vstupy, 8. listopadu byla ukončena terapie linezolidem*, tudíž celkově byla účinná terapie podávána 21 dnů. Kortikoidy detrahovány. Kontrolním ultrazvukovým vyšetřením byl zjištěn výpotek mezi 16–21 mm, nevhodný k punkci, ponecháváme ke spontánní úpravě a observaci. Pacientka byla přeložena na standardní oddělení, kde bylo pokračováno v symptomatické terapii a rehabilitacích. Klinický stav byl zlepšen. V kontrolní laboratoři tendence úpravy jaterních obstrukčních enzymů, amylázy i lipázy, minimální vzestup hodnoty CRP bez klinické korelace. V krevním obraze trvající leukocytóza až 17 × 109/l pravděpodobně při kortikoterapii. Hodnoty trombocytů již skoro normalizovány, duální antiagregace ukončena. Pro epizodu asymptomatické tachykardie byl podán betablokátor. Pacientka byla již dále afebrilní, oběhově stabilizovaná, normosaturovaná. Byla propuštěna do domácí péče za ambulantních pneumologických kontrol.
Při pneumologické kontrole po dvou týdnech si však pacientka stěžuje na přetrvávající potíže. Výrazně se zadýchává při zátěži, musí všechno dělat pomalu. Cítí tlak na hrudníku, bolesti na hrudi nepociťovala. Na kašel nebo úbytek hmotnosti si nestěžovala. Vzhledem k přetrvávajícímu rtg nálezu septovaných výpotků a vzhledem k obtížím pacientky po již absolvované rozsáhlé antibiotické léčbě a drenáži byla multidisciplinárním týmem indikována chirurgická revize. V době uzávěrky článku se pacientka připravovala na elektivní chirurgické dořešení plicního nálezu.
Závěr
Invazivní pneumokokové infekce nepostihují pouze rizikové nemocné nebo seniory, u nichž je indikováno a hrazeno očkování vícevalentními pneumokokovými vakcínami proti pneumokokovým infekcím. Ve výše uvedené kazuistice se jednalo o primárně nerizikovou pacientku. Bakteriemická pneumonie u ní byla komplikována plicními komplikacemi typickými pro pneumokoky, hyposaturací, empyémem, fluidothoraxem s následnou organizací výpotků vyžadující chirurgické řešení navzdory adekvátní antibiotické léčbě. Tato pneumonie nejspíše bude mít dlouhodobý a možná celoživotní dopad na kondici a kvalitu jejího života.
*Výdej léčivého přípravku Zyvoxid je vázán na lékařský předpis. Přípravek je hrazen z prostředků veřejného zdravotního pojištění. Před předepsáním se prosím seznamte s úplnou informací o přípravku na https://www.pfizer.cz/vpois.
MUDr. Zuzana Blechová, Ph.D.1, MUDr. Dita Smíšková, Ph.D.1, MUDr. Miroslav Helcl2
1 Klinika infekčních nemocí 2. LF UK a FN Bulovka
2 Klinika infekčních nemocí FNB a 1., 2. a 3. LF UK, Praha
Korespondenční adresa: blechova.Z@seznam.cz
Literatura
Burgos J, Luján M, Larrosa MN, et al. Risk factors for respiratory failure in pneumococcal pneumonia: the importance of pneumococcal serotypes. Eur RespJ 2014;43:545–553. DOI: 10.1183/09031936.00050413
Chen H, Matsumoto H, Horita N, et al. Prognostic factors for mortality in invasive pneumococcal disease in adult: a system review and meta‑analysis. SciRep 2021;11:11865. doi: 10.1038/s41598‑021‑91234‑y
Kozáková J, Žemličková H, Vohrnová S, Křížová P. Invazivní pneumokokové onemocnění v České republice v roce 2022. Zprávy Centra epidemiologie a mikrobiologie, SZÚ, Praha, 2023;32:261–266.
Kyaw MH, Rose CE Jr, Fry AM, et al. The influence of chronic illnesses on the incidence of invasive pneumococcal disease in adults. J Infect Dis 2005;192: 377–386. https://doi.org/10.1086/431521
Ochoa‑Gondar O, Torras‑Vives V, de Diego‑Cabanes C, et al. Incidence and risk factors of pneumococcal pneumonia in adults: a population‑based study. BMC Pulm Med 2023;23:200. https://doi.org/10.1186/s12890‑023‑02497‑2
Torres A, Cillóniz C, Blasi F, et al. Burden of pneumococcal community‑acquired pneumonia in adults across Europe: a literature review. Respir Med 2018;137:6–13. https://doi.org/10.1016/j.rmed.2018.02.007